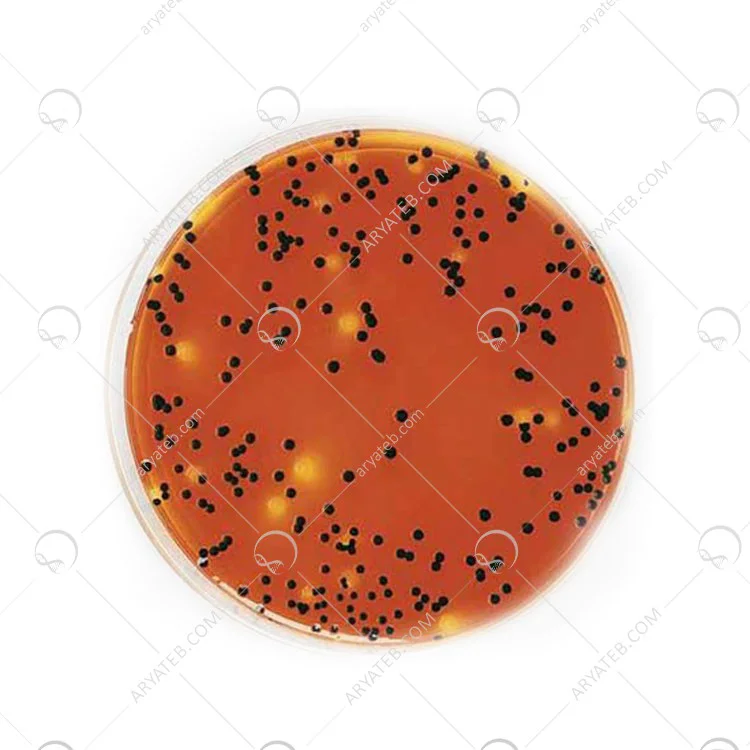

محیط کشت ایندول نیترات
- برای شناسایی میکروارگانیسم های مبتنی بر نیترات ، کاهنده و تولید کننده ایندول استفاده می شود.
محیط کشت Indole Nitrate Medium
محیط کشت Indole Nitrite Medium ، که در فارسی به محیط ایندول نیترات ترجمه می شود. این محیط محیط کشت دیگری است که برای مطالعه و دستیابی به هدف مورد نظر تدوین شده می باشد. همانطور که می دانید مدل های مختلفی از محیط کشت وجود دارد که هر کدام فرمول و ساختار گوناگونی دارند و می توان از آنها برای آزمایش در محیط استفاده کرد.
محیط کشت ایندول نیترات
محیط ایندول نیترات یا (محیط تریپتون نیترات) به دلیل داشتن مواد مغذی از رشد هوازی ، میکروارفیل ها و بی هوازی های اجباری و جلوگیری می کند. هدف این محیط شناسایی تولید و ایندول و کاهش نیترات در طیف گسترده ای از میکروارگانیسم ها می باشد. کازئین هیدرولیزات حاوی تریپتوفان میباشد که تحت تأثیر میکروارگانیسم های خاصی قرار گرفته و منجر به تولید می شود.
ایندول نیترات پتاسیم به عنوان یک بستر برای تعیین کاهش نیترات توسط میکروارگانیسم ها عمل می کند. لوله های کپی ایندول نیترات از محیط را می توان تلقیح و برای نیترات یا ایندول در زمان های مختلف پس از انکوباسیون آزمایش کرد. آزمایش نیترات با افزودن 0.5 میلی لیتر از هر یک از اسیدهای سولفانیلیک (R015) و آلفا نفتیلامین (R009) انجام می شود. رنگ صورتی نشان دهنده کاهش نیترات می باشد. این رنگ به دلیل کاهش نیتریت در محیط رشد می باشد ، هنگامی که سطح نیترات بیشتر است و آمونیاک کاهش می یابد ، هیچ رنگی تولید نمی شود. مقداری پودر روی به لوله اضافه کنید.
تشکیل رنگ صورتی پس از افزودن پودر روی نشان می دهد که نیترات کاهش نمی یابد. تولید ایندول را می توان با افزودن تشکیل رنگ قرمز روشن در لایه ها نشان داد که تست ایندول مثبت است. محیط ایندول نیترات باکتری ها برای آزمایش ایندول در کلی فرم و سایر روده ها توصیه نمی شوند زیرا آنها نیترات را به نیتریت تبدیل می کنند که مانع تشخیص ایندول می شود. از ایندول نیتریت برای تشخیص تولید ایندول توسط اعضای انتروباکتریاسه نباید استفاده کرد. محیط لوله باید به مدت 2 دقیقه جوشانده و قبل از استفاده بدون تحریک سرد گردد.
ترکیبات محیط کشت ایندول نیترات

دستورالعمل تهیه محیط کشت Indole Nitrite Medium
- 25 گرم پودر ایندول نیتریت متوسط را در 1000 میلی لیتر آب مقطر حل کنید.
- مخلوط را گرم کنید تا محیط کاملاً حل شود.
- در لوله های آزمایشگاهی پخش کنید. استریل کردن
- با اتوکلاو در دمای 15 12 121 درجه سانتی گراد به مدت 15 دقیقه استریل سازی کنید
کاربرد محیط کشت ایندول نیترات
محیط نیترات ndole ، که یکسان می باشد (محیط تریپتون نیترات) برای شناسایی میکروارگانیسم های مبتنی بر نیترات ، کاهنده و تولید کننده ایندول استفاده می شود.
خرید محیط کشت Indole Nitrate Medium
این محیط کشت یکی از انواع محیط کشت می باشد که در فروشگاه اینترنتی آریاطب به فروش می رسد. در صورت تمایل به خرید این محیط کشت، می توانید با شماره های ذکر شده در وب سایت با همکاران ما تماس بگیرید تا لیست قیمت کامل این محصول را ارائه دهید.
آدرس ایمیل شما منتشر نخواهد شد. فیلدهای الزامی علامت گذاری شده اند *